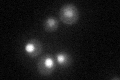
YBR117C
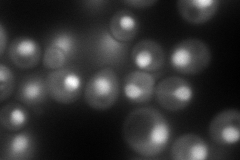
YBR117C
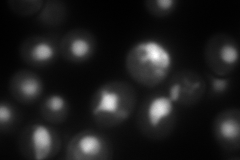
YBR117C
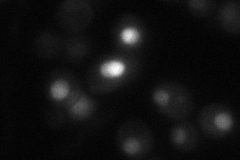
YBR117C
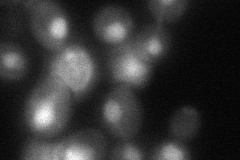
YBR117C

View description
Transketolase, similar to Tkl1p; catalyzes conversion of xylulose-5-phosphate and ribose-5-phosphate to sedoheptulose-7-phosphate and glyceraldehyde-3-phosphate in the pentose phosphate pathway; needed for synthesis of aromatic amino acids
Localization:
Intensity:
Fold change:
Significance:
-
C’ GFP library in SD
nucleus26.56 -
N' NOP1pr-GFP in SD
nucleus231.913 -
N' TEF2pr-mCherry in SD
nucleus282.177 -
N' NATIVEpr-GFP in SD
nucleus26.312 -
N' TEF2pr-VC and Cyto-VN in SD
nucleus67.8656 -
C’ GFP library in SD+DTT

nucleus28.31.06No -
C’ GFP library in SD+H2O2

nucleus31.881.19No -
C’ GFP library in Starvation Media

nucleus99.573.74Yes -
C’ GFP library on the background of Pup2-DaMP

nucleus -
C’ GFP library on the background of CCT mutant

nucleus28.78171.08331No
